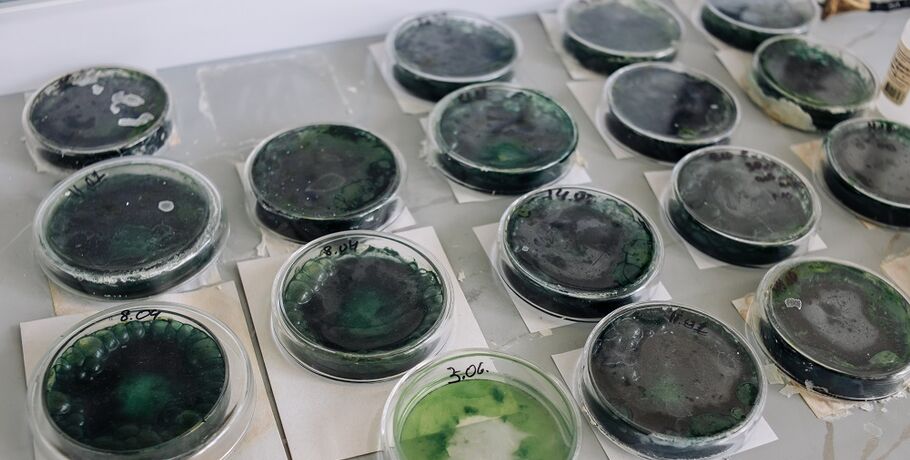
В Омске создали сладости, поднимающие белок и железо

В ОмГТУ создали полезные сладости, обогащённые сибирской водорослью для восполнения дефицита питательных веществ и обладающих повышенной биологической активностью. В линейку "умных" сладостей вошли пастила, снеки, маршмеллоу и желейные конфеты.
Особенностью созданных в ОмГТУ продуктов является наличие в их составе регионального сибирского вида сине-зеленой водоросли - спирулины. По словам исследователей, это позволяет значительно повысить пищевую ценность без ущерба для вкусовых качеств.
- Если выразить данный продукт в цифрах, то можно привести пример с наличием белка. Если в традиционной пастиле белок почти отсутствует, то в нашей разработке содержится спирулина, содержащая 80 процентов полноценного и полностью усвояемого белка. Также продукт содержит большое количество железа, что также важно для организма человека. Мы создаем не просто сладости, а функциональные продукты, которые помогают восполнить дефицит нутриентов. Вместо аптечных витаминов можно перекусить полезной пастилой или маршмеллоу, - рассказала профессор кафедры "Биотехнология, технология общественного питания и товароведение" ОмГТУ Елена Молибога.


В исследовании приняли участие обучающихся направления подготовки бакалавриата "Биотехнология", в частности, студентка третьего курса Анастасия Полякова. По её словам, важной особенностью этой разработки является осуществление полного цикла производства - от выращивания регионального вида спирулины до создания кулинарного изделия. При создании сладких продуктов использовали только локальное сырьё: сибирская спирулина культивируется только в лабораториях ОмГТУ и преобразуется до конечного вида биологически активной добавки за счёт проведения процесса сублимации.
На данный момент учёными полностью разработана технологическая карта производства и отработано внесение всех рецептурных компонентов. После исследователи планируют работать с различными вариантами основы кондитерского изделия - закладывать в неё не только яблочное пюре, но также искать дополнительное сырье, которым богата Омская область.
Напомним, что Елена Молибога была героем нашего подкаста "Наука запросто". Из выпуска с ней вы узнаете, как наука взаимодействует с маркетингом и искусством, зачем разрабатывать новые продукты питания и как оставаться учёным, у которого всегда горят глаза и с которым хотят работать студенты.
Ранее вместе с нутрициологом мы разбирались, какой восточный десерт выбрать тем, кто следит за своей фигурой.
Фото предоставлено отделом по связям с общественностью ОмГТУ